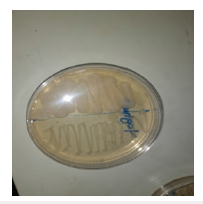
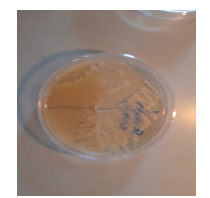
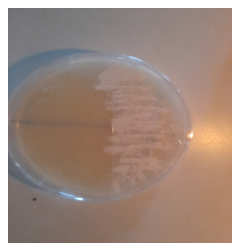
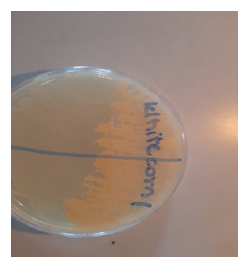
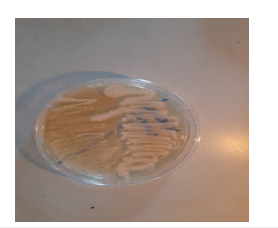
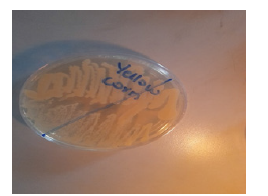
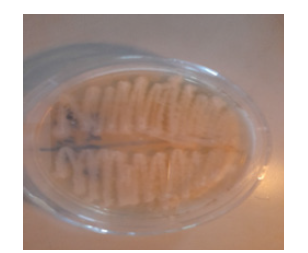

Bassey NS1, Etukudo OM1*, Ekerette EE2, Okonko LE3, Johnny UU1, Job IE2,Nkantion NU4 and Ekanem PJ1
1Department of Biological Sciences, Faculty of Computing & Applied Sciences, Topfaith University, Mkpatak, Nigeria
2Department of Genetics & Biotechnology, Faculty of Biological Sciences, University of Calabar, Nigeria
3Department of Biological Sciences, Faculty of Science, Clifford University, Owerrinta, Nigeria
4Department of Microbiology, Faculty of Biological Sciences, University of Uyo, Nigeria
*Corresponding author:Etukudo OM, Department of Biological Sciences, Faculty of Computing & Applied Sciences, Topfaith University, Mkpatak, Nigeria
Submission: December 05, 2025;Published: December 16, 2025
ISSN:2640-9208Volume8 Issue 5
This study investigated characterization of Ogi Nigerian local lactic acid bacteria (LAB) for functional yoghurt production. Ogi LAB isolates (white corn, yellow corn and brown corn) and yoghurt samples were subjected to morphological, biochemical and sugar fermentation tests. The colony was white or cream-colored, rod- and cocci-form cells, all Gram-positive, which indicates the presence of different LAB species. Biochemical characterization demonstrated predominance for catalase-negative, motility and general failure to grow on citrate or produce hydrogen sulphide, confirming conformity to typical LAB traits. Sugar fermentation tests confirmed extensive carbohydrate metabolism since all isolates fermented glucose, fructose, galactose, lactose, maltose, sucrose, mannose, mannitol and arabinose. The uniform and widespread fermentative profile demonstrates strong enzymatic potential and versatility for both cerealand milk-based substrates. The greater similarity between Ogi-derived and yoghurt-derived isolates indicates that indigenous LAB strains possess equivalent technological characteristics to industrial dairy starter cultures. The findings highlight the potentiality of Ogi LAB as yoghurt starter cultures for generating yoghurt with a capacity to enhance product quality, stability and nutritional values.
Keywords: Ogi; Indigenous fermentation; Yoghurt production; Functional foods; Carbohydrate fermentation; Lactic acid bacteria
The increasing global interest in promoting health through natural diets has stimulated the demand for functional foods. In the food and dairy sectors, the Lactic Acid Bacteria (LAB) are important microorganisms depending on their nutritional, technological and therapeutic significance [1]. They are Gram-positive, catalase-negative, facultative anaerobes and lactateproducers that generate lactic acid as their major end product of carbohydrate metabolism. LAB naturally inhabit areas rich in carbohydrates like plants, fermented food and animal and human mucosal surfaces [2]. Members of the group encompass species from Lactobacillus, Lactococcus, Leuconostoc, Streptococcus and Enterococcus genera [3]. LAB are traditionally responsible for playing a core role in fermentation owing to their ability to enhance food preservation, flavor, taste and texture [4]. They extend shelf life and improve food safety by yielding organic acids, hydrogen peroxide, ethanol, carbon dioxide and antimicrobial peptides such as bacteriocins [5]. Their long centuries of safe use bestowed upon them a “Generally Recognized as Safe” (GRAS) status and therefore a peculiar value in food biotechnology [6]. In addition to their technological application, the majority of LAB strains serve as probiotics, offering benefits such as modulation of gut microbiota, cholesterol reduction, increased lactose utilization, immune stimulation and anticarcinogenic effect [7]. Yoghurt, the most popular fermented milk product, is a consequence of LAB-mediated lactose fermentation. It is an excellent carrier and source of nutrition as well as having varied textures and flavors to enhance its popularity across the globe [8]. Some LAB strains also strengthen yoghurt by generating essential vitamins like riboflavin, niacin and folic acid, thus providing a natural alternative to artificial fortification [9]. Different LAB strains also produce bioactive molecules, commonly known as nutraceuticals, that improve health by exemplifying antioxidant activity, Angiotensin-Converting Enzyme (ACE) inhibition and other protective effects [7]. Fermented foods are reservoirs for diverse LAB strains with unique properties [7]. Ogi, a fermented cereal food that is very common in Nigeria, is a good source of native LAB especially. LAB have been isolated before from such foods to be applied in probiotics, enzyme production and the formulation of functional food ingredients [4]. Yet, there is limited information on the characterization of Ogi LAB for yoghurt functional production. Exploration of these indigenous microorganisms may enhance the nutritional and functional properties of yoghurt and establish value in traditional African fermented foods.
Source of materials
The materials used for isolation of Lactic Acid Bacteria (LAB) consisted of yoghurt (fermented milk product) and Ogi (traditional maize porridge, Zea mays). The samples were randomly purchased from four locations in Offiong Market, Essien Udim Local Government Area, Akwa Ibom State, Nigeria. The samples were subsequently transferred to the Biological Sciences Laboratory, Topfaith University, under aseptic conditions for subsequent analysis.
Sample preparation
The samples were homogenized with sterile peptone physiological saline solution following microbiological analysis. Specifically, 1mL yoghurt was mixed with 9mL of the diluent, while 1g of Ogi was homogenized separately in 10mL of the same solution [3].
Media preparation
According to the manufacturer’s guide, 67.1g of de Man Rogosa Sharpe (MRS) medium was dissolved in 1000mL of distilled water. The solution was heated gently until dissolved completely and later sterilized by autoclave under 121 °C and 15 psi for 15 minutes. After cooling at room temperature, the medium was poured into sterile Petri dishes. For the preparation of MRS broth, an equal amount of medium (67.1g) was dissolved in 1000mL distilled water, but the agar part was filtered out before sterilization.
Isolation of lactic acid bacteria from fermented Ogi
Fermented Ogi were homogenized in sterile buffered peptone water, serially diluted and plated on MRS agar. Plates were incubated anaerobically at 37 °C for 48 hours and representative colonies were streaked on fresh MRS agar for purification. Isolates that formed yellow zones were presumptively identified as LAB and identified further by Gram staining, motility and catalase tests. Pure Gram-positive rod-shaped colonies were kept on MRS agar slants at 4 °C for long-term storage [10,11].
Gram staining
Gram staining was performed to determine the reaction of the isolates. Smears were collected on grease-free clean slides, heatfixed and sequentially treated with crystal violet (60 s), Lugol’s iodine (60 s), acetone for rapid decolorization and safranin (2min), following each by rinsing. The slides were air-dried and examined in an oil immersion objective (×100) to differentiate Gram-positive from Gram-negative organisms [12].
Biochemical tests
For further identification, the isolates were subjected to a series of biochemical tests following the procedure described by [3].
Catalase test
About 2ml of 3% hydrogen peroxide solution was added to a sterile test tube. With the help of a sterile wooden applicator, a portion of the actively growing culture was inoculated into the solution. Absence of effervescence indicated a negative result, which meant catalase was not synthesized, while the production of instantaneous bubbles ensured a positive result, pointing towards the catalase activity.
Motility test
Motility test was conducted to check whether the bacterial isolates were able to move. A single colony of bacteria was inoculated in MRS agar medium contained in a test tube and incubated at 37 °C for 48 hours. Motility was established based on evidence of the growth pattern: lines constrained within the inoculation line were found to be non-motile (negative) and those spreading within the medium or along its surface were considered motile (positive).
Citrate utilization test
The isolates were first cultured in peptone water and anaerobically incubated at 37 °C for 24 hours. Thereafter, a sterile wire loop was used to inoculate broth culture into 4ml of sterile Koser’s citrate medium. The tubes were incubated for up to four days at 37 °C in anaerobic conditions, the screw caps loosened slightly to allow gas exchange. Daily monitoring was done to observe the cultures for any evidence of growth. Appearance of turbidity with blue color was taken as an indication of the use of citrate.
Hydrogen sulphide production
2μL culture of all Lactic Acid Bacteria (LAB) isolates was streaked on Triple Sugar Iron (TSI) agar medium and incubated at 30 °C for 48 hours. Presence of black color at the point of inoculation was an indication of hydrogen sulphide production.
Sugar fermentation test
Isolates were first cultured in MRS broth anaerobically at 37 °C for 24 hours. 4 ml of the newly prepared MRS broth with 2ml of 10% sugar solution (glucose, fructose, lactose, mannose, sucrose, maltose, or galactose) containing an inverted Durham tube was inoculated with the isolates overnight culture. The tubes were kept anaerobically at 37 °C for an additional 24 hours. Sugar fermentation was shown by a color change in the medium and bubbles in the Durham tubes.
Pasteurization of the milk and inoculation with selected LAB strains
A hundred milliliters (100ml) of milk was measured using a graduated cylinder. Pasteurization was carried out at 88 °C for 15 minutes because pasteurization is a critical step in yogurt processing due to its effect on the physical and structural properties of the end product [3]. Heat treatment of the milk during yogurt production is always performed before starter cultures are added. Controlled time-temperature regimes which are commonly applied in the industry include heating at 85 °C for 30 minutes or 90-95 °C for 5 minutes [13]. In some cases, more intensive treatments in the form of very high temperature short time (100-130 °C for 4-16 s) or Ultra-Heat Treatment (UHT) at 140 °C for 4-16 s are utilized [13]. Pasteurization serves to accomplish the two purposes of removing unwanted microorganisms and reducing oxygen levels in milk, thereby enhancing starter culture performance since yogurt bacteria are susceptible to oxygen. The milk was chilled to the inoculation temperature optimal for the development of the starter after heat treatment. The starter culture preparation was a 10⁻⁷ serial dilution of the isolate following 24-hour subculturing. 1ml of the seventh dilution tube was added to chilled milk, which was then incubated for 19 hours at 37 °C.
Incubation and fermentation
The inoculated milk was incubated at 37 °C for 19 hours to enable complete fermentation by the starter culture. Following incubation, the yogurt was transferred to a refrigerator and cooled for 2 hours in order to halt further bacterial activity and stabilize the product [3].
Morphological identification test of lactic acid bacteria (LAB)
Morphological description of LAB isolates from Ogi and yoghurt samples is presented in Table 1 and Figures 1-8. Colony colour was either white or cream, varying from one sample to another. Rods and cocci were identified from cell shape analysis, while Gram staining proved that they were all Gram-positive.
Table 1:Morphological identification test of Lactic Acid Bacteria (LAB).

Figure 1:Yogurt colony.
Figure 2:Brown corn colony.
Figure 3:Yogurt B colony.
Figure 4:White corn 1 colony.
Figure 5:White corn 2 colony.
Figure 6:Yellow corn colony.
Figure 7:Yogurt 2 colony.
Figure 8:Positive Gram staining result.

The predominance of white and cream colours of the colonies are typical of LAB, which form white or cream-colored colonies on growth medium [3]. The presence of both rod and cocci forms indicates the presence of diverse LAB species in the samples, likely containing Lactobacillus (rods), Pediococcus and Streptococcus (cocci) and Leuconostoc species [14-16]. The universal Grampositive test by all the isolates also establishes their identification as LAB, as members of this group are usually Gram-positive, nonspore- forming organisms [3]. These findings are in accord with earlier descriptions of LAB from fermented cereal (Ogi) and milk foods as heterogeneous in morphology but monomorphically Gram-positive [2]. Diversity of colony colour and cell shape in the observed diversity suggests coexistence of a mixture of a number of LAB genera in both cereal and milk fermentations and may be accountable for the peculiar organoleptic and nutritional properties of the fermented foods [4].
The biochemical characterization of LAB isolates from Ogi and yoghurt samples
The results of the biochemical characterization of LAB isolates are presented in Table 2. The catalase test indicated both positive and negative reactions (Figure 9) among the isolates, while all isolate tested positive for motility (Figure 10). None of the isolates were able to utilize citrate (Figure 11) and all were negative for hydrogen sulphide production (Figure 12).
Table 2:Biochemical tests.

Figure 9:Positive and Negative catalase results.

Figure 10:Positive motility result.

Figure 11:Negative citrate utilization result.

Figure 12:Negative hydrogen sulphide production.

The biochemical test results for Lactic Acid Bacteria (LAB) isolates of yoghurt and Ogi samples are summarized in Table 2 and Figures 9-12. Isolates varied in catalase test; some were catalasepositive (White corn 1A, Yoghurt 2A, Yellow corn A, Yoghurt B, White corn B), while others were catalase-negative. However, all the isolates were motile, indicating a persistent ability to move. All the isolates failed to grow on citrate as a source of carbon and were negative for hydrogen sulphide production. The catalasenegative dominance is consistent with the expected characteristics of LAB, which are usually catalase-negative due to the absence of cytochromes [17]. Catalase-positive reaction in some isolates may be attributed to the manifestation of pseudo-catalase activity, as seen in some described instances of Lactobacillus and Leuconostoc species [3,18]. The motility of all the isolates suggests that these isolates can include species whose mobility is flagella-mediated and therefore may help in substrate colonization [19]. The inability of the isolates to ferment citrate and emit hydrogen sulphide both further their identification as LAB, since such organisms do not typically harbor enzymatic equipment for such metabolisms [20]. These biochemical patterns coupled with sugar fermentation patterns confirm the isolates’ conformities to typical LAB characteristics, further pointing to their promise as safe and viable microorganisms for food fermentation [3].
Sugar fermentation test revealed that all the LAB isolates obtained from Ogi (white corn, yellow corn, brown corn) and yoghurt samples possessed a general ability to ferment a broad range of sugars such as mannose, arabinose, lactose, glucose, galactose, sucrose, mannitol, fructose and maltose (Table 3). Each of the isolates gave a positive result (+) for all the tested carbohydrates and none of the results were negative. Such a uniform pattern of sugar utilization across the isolates indicates extensive fermentative capacity and strong enzymic potential [21]. Such metabolic adaptability is a characteristic feature of LAB, which are known to harness different monosaccharides and disaccharides effectively by glycolytic and related pathways with lactic acid as the major end product [22]. General hexose fermentation of glucose, fructose and galactose was expected as they are central molecules in energy metabolism, while the ability to ferment lactose, maltose and sucrose demonstrates the uniqueness of the isolates in feeding on both cereal-substrate (Ogi) and milk-substrate (yoghurt) [23]. The similarity of the fermentative pattern between Ogi-derived and yoghurt-derived isolates reflects that LAB obtained from indigenous cereal fermentations in their traditional environments possess the same technological qualities as the applied strains during dairy fermentations [17]. This substantiates previous findings that indigenous Lactobacillus, Leuconostoc and Pediococcus genera are capable of fermenting a broad spectrum of sugars and thereby enhancing their functional potential in food products [24]. Their ability to metabolize mixed carbohydrates indicates that they are suitable as potential starter cultures for yoghurt manufacture, with the capacity to enhance product stability, quality and nutritional value [16]. As yoghurt starter cultures, Ogi-derived LAB demonstrate technological characteristics comparable to those of industrial dairy starter cultures [25]. In addition, the use of Ogi LAB may be particularly relevant for modulating gram-negative bacteria that release lipopolysaccharides (LPS) [25]. Consequently, incorporating Ogi LAB as a yoghurt starter culture may contribute to reducing plasma LPS levels in individuals with various chronic diseases [26]. The ability of the whole isolates to ferment a wide range of sugars suggests that lactic acid bacteria from Ogi and yoghurt are metabolically heterogeneous and endowed with powerful enzymatic machinery for carbohydrate utilization. This is consistent with the earlier findings on lactic acid bacteria, in which Lactobacillus, Leuconostoc, Pediococcus and Streptococcus species were recorded as efficient mono-and disaccharide fermenters [27].
Table 3:Sugar fermentation test.

The overall fermentation of glucose, fructose and galactose by the isolates is expected, as they are generic hexose sugars readily metabolized through glycolytic pathways to yield lactic acid as the principal end product. Fermentation capacity for lactose, sucrose and maltose also suggests the potential of these isolates in cereal as well as milk-based substrates and their usability in functional foods such as the production of yoghurt [28]. Interestingly, the consistent positive reaction among isolates and sugars might be a sign that LAB populations in Ogi have similar metabolic traits to those in yoghurt. This shows that traditional cereal fermentations have LAB strains of similar technological traits to those used that are implemented in industrial dairy fermentations. The versatility is useful for functional product development because they can survive on different carbohydrate substrates and yet produce optimal fermentation traits [29]. The findings therefore highlight the suitability of indigenous LAB isolates derived from Ogi as potential starter cultures for yoghurt production, capable of enhancing product quality, stability and nutritional value.
Characterization of the lactic acid bacteria from Ogi revealed a heterogeneous population of Gram-positive rod-and coccishaped isolates, which possessed common LAB features like catalase-negative predominance, inability to utilize citrate and non-production of hydrogen sulphide. Their ability to ferment a wide variety of carbohydrates points to their metabolic versatility and potential as food fermentative agents. Most importantly, the similarity in fermentative characteristics between cereal and milk isolates confirms the authenticity of indigenous Ogi LAB as functional starter cultures for yoghurt production. The use of these indigenous strains provides the opportunity for diversification of yoghurt production based on locally accessible cultures, nutritional quality enhancement and preservation of traditional fermentation knowledge. Molecular characterization and probiotic analysis must be taken into consideration for future research to confirm their industrial application and health benefits.
Statement of Conflict of interest
The authors have made the declaration that there are no conflicts of interest with this publication.
© 2025 Etukudo OM. This is an open access article distributed under the terms of the Creative Commons Attribution License , which permits unrestricted use, distribution, and build upon your work non-commercially.
a Creative Commons Attribution 4.0 International License. Based on a work at www.crimsonpublishers.com.
Best viewed in